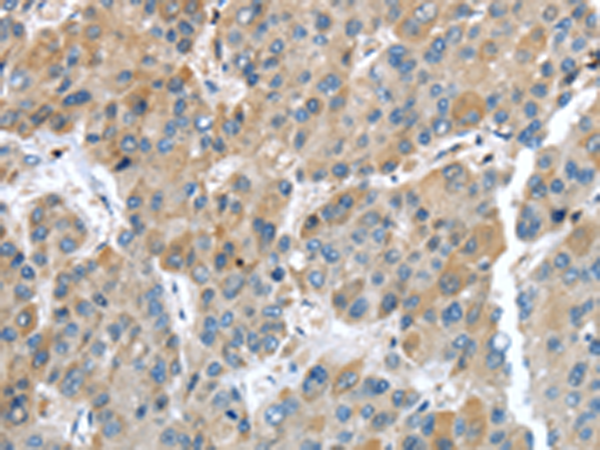

|
IHC Recommend dilution: |
25-100 |
|
IHC positive control: |
Human liver cancer and human breast cancer |
|
ELISA Recommended dilution: |
2000-5000 |
|
SwissProt: |
P22692 |
|
Synonyms: |
BP-4; IBP4; IGFBP-4; HT29-IGFBP |
|
Full name: |
insulin-like growth factor binding protein 4 |
|
Immunogen: |
Fusion protein of human IGFBP4 |
|
Name of antibody: |
IGFBP4 |
|
Applications: |
ELISA, IHC |
|
Background: |
This gene is a member of the insulin-like growth factor binding protein (IGFBP) family and encodes a protein with an IGFBP domain and a thyroglobulin type-I domain. The protein binds both insulin-like growth factors (IGFs) I and II and circulates in the plasma in both glycosylated and non-glycosylated forms. Binding of this protein prolongs the half-life of the IGFs and alters their interaction with cell surface receptors. |

購物車
幫助
021-54845833/15800441009
